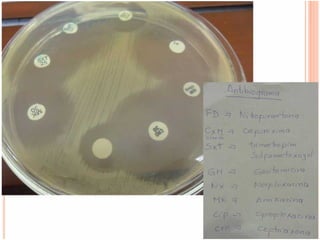

El documento describe los resultados característicos de las pruebas de TSI, LIA, MIO y otras pruebas bioquímicas y de laboratorio para la identificación de bacterias como E. coli, Proteus mirabilis, Acinetobacter, Shigella, Salmonella, Pseudomonas y Klebsiella. También describe hallazgos microscópicos de parásitos como Ascaris lumbricoides y huevos/quistes de otros parásitos. Finalmente, menciona medios de cultivo y tinciones para el diagnóstico de infecciones.